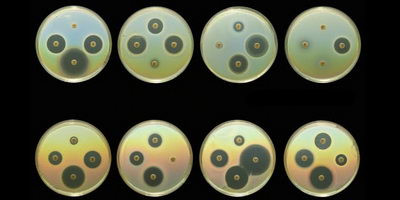
Результати масштабного дослідження антибіотикорезистентності СОАР в Україні

Бактеріофаги в лікуванні стафілококового маститу
Мастит (запалення молочної залози) у молочних корів – проблема, яка веде до значних збитків фермерських господарств, а також є причиною надмірного використання антибіотиків та, відповідно, поширення антибіотикорезистентності.